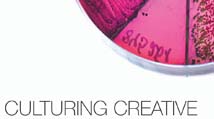

Martha Bartlett Piland launches book for financial brands: Beyond Sticky.
Martha Bartlett Piland launches book for financial brands: Beyond Sticky.
For every banker who wants to get off the commodity hamster wheel, Beyond Sticky, by Martha Bartlett Piland, is a first-of-its-kind book on bank marketing, innovation and branding. It’s filled with guidance on building a value-driven brand by connecting all departments in the bank.
A guidebook for fostering the curiosity and creativity that solve everyday problems.
Creativity solves problems, engineers spaceships, builds brands and more. It makes everything go.



